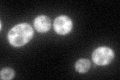
YER151C
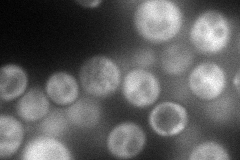
YER151C
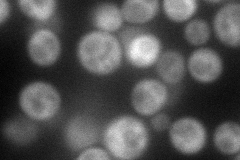
YER151C
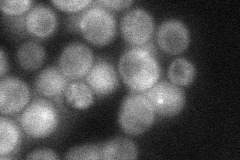
YER151C
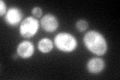
YER151C
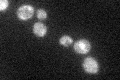
YER151C

View description
Ubiquitin-specific protease that interacts with Bre5p to co-regulate anterograde and retrograde transport between endoplasmic reticulum and Golgi compartments; inhibitor of gene silencing; cleaves ubiquitin fusions but not polyubiquitin
Localization:
Intensity:
Fold change:
Significance:
-
C’ GFP library in SD
cytosol69.67 -
N' NOP1pr-GFP in SD
cytosol88.1907 -
N' TEF2pr-mCherry in SD
cytosol103.19 -
N' NATIVEpr-GFP in SD
cytosol37.254 -
N' TEF2pr-VC and Cyto-VN in SD

cytosol50.5244 -
C’ GFP library in SD+DTT
cytosol75.791.08No -
C’ GFP library in SD+H2O2

cytosol73.941.06No -
C’ GFP library in Starvation Media
cytosol42.630.61No -
C’ GFP library on the background of Pup2-DaMP

cytosol -
C’ GFP library on the background of CCT mutant

cytosol74.64891.07129No
